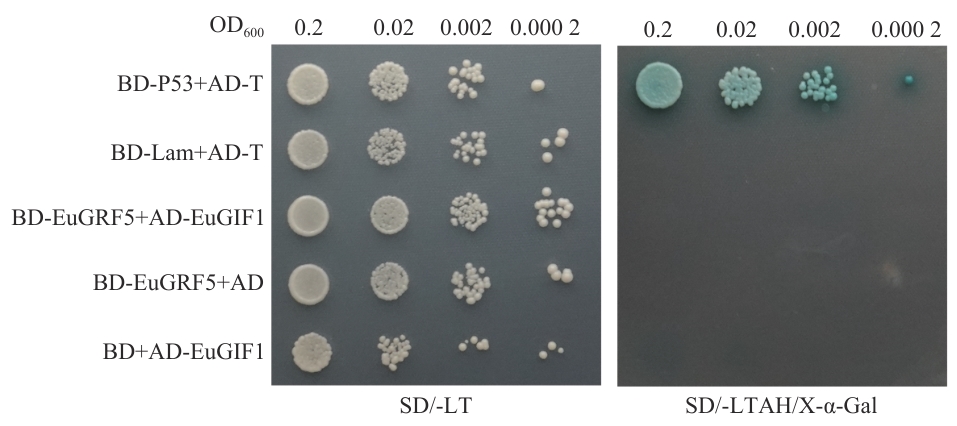

生物技术通报 ›› 2025, Vol. 41 ›› Issue (12): 267-279.doi: 10.13560/j.cnki.biotech.bull.1985.2025-0438
王若若1,2( ), 曲鹏坤1, 张欣1, 王珞1, 朱英1, 田双一3, 赵德刚2,4(
), 曲鹏坤1, 张欣1, 王珞1, 朱英1, 田双一3, 赵德刚2,4( )
)
收稿日期:2025-04-24
出版日期:2025-12-26
发布日期:2026-01-06
通讯作者:
赵德刚,男,博士,教授,研究方向 :杜仲功能基因及高值利用;E-mail: dgzhao@gzu.edu.cn作者简介:王若若,女,博士,助理研究员,研究方向 :植物功能基因;E-mail: ruozhu_w@163.com
基金资助:
WANG Ruo-Ruo1,2( ), QU Peng-Kun1, ZHANG Xin1, WANG Luo1, ZHU Ying1, TIAN Shuang-Yi3, ZHAO De-Gang2,4(
), QU Peng-Kun1, ZHANG Xin1, WANG Luo1, ZHU Ying1, TIAN Shuang-Yi3, ZHAO De-Gang2,4( )
)
Received:2025-04-24
Published:2025-12-26
Online:2026-01-06
摘要:
目的 基于杜仲(Eucommia ulmoides Oliv.)全基因组数据,系统鉴定GIF(GRF-interacting factor)基因家族成员,分析GIF基因家族成员基因表达模式及蛋白互作特性,为解析杜仲器官发育调控网络及优化杜仲的遗传转化体系提供理论依据。 方法 利用HMMER和BLASTP方法鉴定杜仲GIF基因家族成员,结合生物信息学工具分析蛋白理化性质、三维结构及启动子顺式元件;通过RT-qPCR检测基因组织特异性及赤霉素GA₃诱导表达模式;采用酵母双杂交(Y2H)和双分子荧光互补(BiFC)实验验证EuGIF1与EuGRF5的互作关系;此外,用EuGIF1基因的过表达载体对拟南芥gif1突变体进行遗传互补。 结果 在杜仲的基因组中共鉴定到了3个EuGIF基因,EuGIF1、EuGIF2和EuGIF3,其中,EuGIF1和EuGIF2位于杜仲基因组的7号染色体,EuGIF3位于杜仲基因组的17号染色体。EuGIF1、EuGIF2和EuGIF3编码的蛋白均含保守的SSXT/SNH结构域。启动子序列分析显示,EuGIF1基因的启动子区域含有2个赤霉素响应元件。EuGIF1在顶端分生组织中高表达且受赤霉素GA₃快速诱导;蛋白的三维结构预测显示SSXT/SNH结构域可形成蛋白互作界面。共表达分析表明EuGIF1与EuGRF1/3/5表达模式相似,但Y2H和BiFC实验均未检测到EuGIF1与EuGRF5的直接互作。此外,EuGIF1基因在拟南芥中的过表达无法互补拟南芥gif1突变体中叶片窄小的表型。 结论 EuGIF1可能在赤霉素信号介导的杜仲器官发育中发挥重要作用,GIF1与GRF的互作可能具有物种特异性,且基因功能的保守性在不同物种之间存在一定的局限性。
王若若, 曲鹏坤, 张欣, 王珞, 朱英, 田双一, 赵德刚. 杜仲EuGIF1基因鉴定及其表达和蛋白互作分析[J]. 生物技术通报, 2025, 41(12): 267-279.
WANG Ruo-Ruo, QU Peng-Kun, ZHANG Xin, WANG Luo, ZHU Ying, TIAN Shuang-Yi, ZHAO De-Gang. Molecular Characterization, Expression Profiling, and Protein Interaction Analysis of the EuGIF1 Gene in Eucommia ulmoides[J]. Biotechnology Bulletin, 2025, 41(12): 267-279.
引物名称 Primer name | 序列 Sequence (5′‒3′) |
|---|---|
| cdsEuGIF1-F | ctagaggatctcgaggcATGCAGCAGCACCTGATG |
| cdsEuGIF1-R | cgtctgtacacctaggTCAGTTTCCATCATCAGAA |
| EuGIF1gfp-F | ttggagaggacacgcATGCAGCAGCACCTGATG |
| EuGIF1gfp-R | cttctcccttacccatGTTTCCATCATCAGAAGCCT |
| YN-GIF1-F | gcatttaaatctcgaggATGCAGCAGCACCTGATG |
| YN-GIF1-R | gtggcgatggatcttctGTTTCCATCATCAGAAGC |
| YC-GRF5-F | gaggaggacctgctttATGAACGTGAACGCGATGA |
| YC-GRF5-R | acgccggacgggtaccgCCAGTAGGGTCTGGAGT |
| AD-GIF1-F | ggccatggaggccagtATGCAGCAGCACCTGATG |
| AD-GIF1-R | gcagctcgagctcgatGTTTCCATCATCAGAAGCC |
| BD-GRF5-F | tatggccatggaggccATGAACGTGAACGCGATGA |
| BD-GRF5-R | gccgctgcaggtcgacCCAGTAGGGTCTGGAGTT |
| YS22-GFP-R | aggaagctttccagtagtgca |
| termi-R | aagaccggcaacaggattc |
| cdsEuGIF1-F2 | CAGCTGGGAATGAGCTCTGG |
| EuGIF1-qRT-F | CAGCAGTATTCGGCACTACAG |
| EuGIF1-qRT--R | CCTCCACTCCCACCCATT |
| EuGIF2-qRT--F | CCATCACCAGCAGCATCAAT |
| EuGIF2-qRT--R | CACCGCCACCTCCGATAT |
| EuGIF3-qRT--F | ACAATGGCTCAGCAACAACA |
| EuGIF3-qRT--R | GTGGTGGAAGTGGAGTAGGT |
| EuACTIN-qRT--F | GTGTTATGGTTGGGATGGG |
| EuACTIN-qRT--R | TGCTGACTATGCCGTGTTC |
表1 引物序列表
Table 1 Table of primer sequences
引物名称 Primer name | 序列 Sequence (5′‒3′) |
|---|---|
| cdsEuGIF1-F | ctagaggatctcgaggcATGCAGCAGCACCTGATG |
| cdsEuGIF1-R | cgtctgtacacctaggTCAGTTTCCATCATCAGAA |
| EuGIF1gfp-F | ttggagaggacacgcATGCAGCAGCACCTGATG |
| EuGIF1gfp-R | cttctcccttacccatGTTTCCATCATCAGAAGCCT |
| YN-GIF1-F | gcatttaaatctcgaggATGCAGCAGCACCTGATG |
| YN-GIF1-R | gtggcgatggatcttctGTTTCCATCATCAGAAGC |
| YC-GRF5-F | gaggaggacctgctttATGAACGTGAACGCGATGA |
| YC-GRF5-R | acgccggacgggtaccgCCAGTAGGGTCTGGAGT |
| AD-GIF1-F | ggccatggaggccagtATGCAGCAGCACCTGATG |
| AD-GIF1-R | gcagctcgagctcgatGTTTCCATCATCAGAAGCC |
| BD-GRF5-F | tatggccatggaggccATGAACGTGAACGCGATGA |
| BD-GRF5-R | gccgctgcaggtcgacCCAGTAGGGTCTGGAGTT |
| YS22-GFP-R | aggaagctttccagtagtgca |
| termi-R | aagaccggcaacaggattc |
| cdsEuGIF1-F2 | CAGCTGGGAATGAGCTCTGG |
| EuGIF1-qRT-F | CAGCAGTATTCGGCACTACAG |
| EuGIF1-qRT--R | CCTCCACTCCCACCCATT |
| EuGIF2-qRT--F | CCATCACCAGCAGCATCAAT |
| EuGIF2-qRT--R | CACCGCCACCTCCGATAT |
| EuGIF3-qRT--F | ACAATGGCTCAGCAACAACA |
| EuGIF3-qRT--R | GTGGTGGAAGTGGAGTAGGT |
| EuACTIN-qRT--F | GTGTTATGGTTGGGATGGG |
| EuACTIN-qRT--R | TGCTGACTATGCCGTGTTC |

图1 杜仲EuGIFs蛋白序列分析及基因在染色体上的分布A:EuGIFs蛋白序列中保守结构域的分布;B:EuGIFs蛋白的氨基酸序列比对;C:EuGIFs基因在染色体上的分布
Fig. 1 Distribution of conserved domains in the EuGIFs protein sequences and chromosomal distribution of the genes in E. ulmoidesA: Distribution of conserved domains in the EuGIFs protein sequences. B: Amino acid sequence alignment of EuGIFs proteins. C: Chromosomal distribution of the EuGIFs genes
基因 名称 Gene name | 基因ID Gene ID | 氨基酸长度 Number of amino acids (aa) | 蛋白分子量 Molecular weight (Da) | 等电点 Theoretical pI | 不稳定指数 Instability index | 脂肪族氨基酸指数 Aliphatic index | 疏水性平均值 Grand average of hydropathicity | 亚细胞定位 Subcellular location |
|---|---|---|---|---|---|---|---|---|
| EuGIF1 | evm.model.Chr7.1262 | 203 | 22 275.03 | 6.62 | 61.24 | 59.26 | -0.833 | Nucleus |
| EuGIF2 | evm.model.Chr7.1483 | 198 | 21 579.25 | 6.01 | 83.45 | 64.14 | -0.565 | Nucleus |
| EuGIF3 | evm.model.Chr17.1343 | 214 | 22 651.04 | 5.84 | 71.27 | 54.86 | -0.678 | Nucleus |
表2 杜仲EuGIFs蛋白理化性质
Table 2 Physicochemical properties of the EuGIFs proteins in E. ulmoides
基因 名称 Gene name | 基因ID Gene ID | 氨基酸长度 Number of amino acids (aa) | 蛋白分子量 Molecular weight (Da) | 等电点 Theoretical pI | 不稳定指数 Instability index | 脂肪族氨基酸指数 Aliphatic index | 疏水性平均值 Grand average of hydropathicity | 亚细胞定位 Subcellular location |
|---|---|---|---|---|---|---|---|---|
| EuGIF1 | evm.model.Chr7.1262 | 203 | 22 275.03 | 6.62 | 61.24 | 59.26 | -0.833 | Nucleus |
| EuGIF2 | evm.model.Chr7.1483 | 198 | 21 579.25 | 6.01 | 83.45 | 64.14 | -0.565 | Nucleus |
| EuGIF3 | evm.model.Chr17.1343 | 214 | 22 651.04 | 5.84 | 71.27 | 54.86 | -0.678 | Nucleus |

图2 EuGIFs蛋白的三维空间结构图A:EuGIFs蛋白的三维结构的卡通图;箭头指向的区域为SSXT/SNH结构域的区域;B:EuGIFs蛋白的三维表面结构图;箭头指示的是pLDDT值大于90的氨基酸,对应A图中棍状结构显示的氨基酸
Fig. 2 Three-dimensional spatial structure diagram of the EuGIFs proteinA: Cartoon representation of the 3D structure of EuGIFs protein. Regions corresponding to the SSXT/SNH domains are indicated by arrows. B: Surface representation of the 3D structure of EuGIFs protein. The arrows denote the amino acids with pLDDT (predicted local distance difference test) values>90, which correspond to the amino acids depicted as stick structures in Fig. A

图4 杜仲EuGIFs基因的表达模式A:杜仲EuGIFs基因在杜仲各组织部位的表达情况;B:杜仲幼苗在喷施GA3后,幼叶中EuGIFs基因的表达情况;***P<0.001、ns表示没有显著差异(P>0.05)
Fig. 4 Expression pattern of EuGIFs genes in E. ulmoidesA: Expression profiles of the EuGIFs gene in different tissues of E. ulmoides. B: Expression profiles of the EuGIFs gene in young leaves of seedlings following exogenous GA3 treatment. *** P<0.001, ns indicates no statistically significant difference (P>0.05)

图5 GIF同源蛋白的系统发育分析及EuGIF与EuGRFs的基因共表达模式A:基于蛋白序列全长构建的邻接法系统进化树;所有蛋白均包含保守的SNH/SSXT结构域,绿色阴影部分为AtGIF1的同源蛋白,红色标注的是EuGIF1;蛋白名称中的物种缩写Eu、Cc、At、Vv、Cl、Fve、Os、Ta分别对应杜仲、柑橘、拟南芥、葡萄、西瓜、二倍体野生草莓、水稻、普通小麦;B:EuGIFs和EuGRFs的基因表达模式;红虚线框表示分生组织高表达且模式相似的基因,颜色梯度表示表达量(蓝‒黄‒红:低‒中‒高)
Fig. 5 Phylogenetic analysis of GIF homologs and gene co-expression profiles of EuGIF and EuCRFsA: Neighbor-joining phylogenetic tree constructed using full-length protein sequences, with all proteins containing the conserved SNH/SSXT domain. The green-shaded region highlights AtGIF1 homologs, and EuGIF1 is marked in red. The species abbreviations in the protein names, Eu, Cc, At, Vv, Cl, Fve, Os, and Ta, correspond to Eucommia ulmoides, Citrus clementina, Arabidopsis thaliana, Vitis vinifera, Citrullus lanatus, Fragaria vesca, Oryza sativa, and Triticum aestivum, respectively. B: Expression patterns of EuGIFs and EuGRFs, with the red dashed box indicating genes having high and correlated expression in meristematic tissues. The color gradient (blue-yellow-red) indicate expression levels (low-medium-high) of EuGRFs

图6 GFP融合蛋白在烟草叶片下表皮细胞中的亚细胞定位图中展示4个成像通道:GFP(绿色,激发光/发射光:488/510 nm)、叶绿体自发荧光(红色,激发光/发射光:640/675 nm)、明场和合并图像。图中比例尺均为50 μm
Fig. 6 Subcellular localization of GFP-tagged proteins in the epidermal cells of tobacco leafThe figure displays four imaging modalities: GFP fluorescence (green, excitation/emission: 488/510 nm); chloroplast autofluorescence (red, excitation/emission: 640/675 nm); bright field (grayscale) and merged image. Scale bar: 50 μm
蛋白模型编号 Number | 结构偏差 RMSD (Å) | 亲和力 Score |
|---|---|---|
| 1 | 50.52 | -809.33 |
| 2 | 31.22 | -774.96 |
| 3 | 69.01 | -764.03 |
| 4 | 60.97 | -758.89 |
| 5 | 55.71 | -755.58 |
| 6 | 79.41 | -749.46 |
| 7 | 64.33 | -747.77 |
| 8 | 62.85 | -735.99 |
| 9 | 62.97 | -732.66 |
| 10 | 68.86 | -732.20 |
表3 用HDOCK预测的EuGIF1-EuGRF5蛋白互作结构分析结果
Table 3 Structural analysis of EuGIF1-EuGRF5 protein-protein interaction predicted by HDOCK
蛋白模型编号 Number | 结构偏差 RMSD (Å) | 亲和力 Score |
|---|---|---|
| 1 | 50.52 | -809.33 |
| 2 | 31.22 | -774.96 |
| 3 | 69.01 | -764.03 |
| 4 | 60.97 | -758.89 |
| 5 | 55.71 | -755.58 |
| 6 | 79.41 | -749.46 |
| 7 | 64.33 | -747.77 |
| 8 | 62.85 | -735.99 |
| 9 | 62.97 | -732.66 |
| 10 | 68.86 | -732.20 |
图7 EuGIF1与EuGRF5的酵母双杂交互作验证SD/-LT:亮氨酸(-L)和色氨酸(-T)双重缺陷型合成培养基;SD/-LTAH/X-α-Gal:添加5-溴-4-氯-3-吲哚基-α-D-吡喃半乳糖苷的四重缺陷型(-L/-T/-A/-H)严格筛选培养基;图上标注的OD600值(0.2、0.02、0.002、0.000 2)代表点种实验前酵母的10倍梯度稀释浓度;阳性对照组:BD-P53+AD-T;阴性对照组1:BD-Lam+AD-T,结果与阳性对照组结合验证实验室实验系统的稳定性;实验组:BD-EuGRF5+AD-EuGIF1;阴性对照组2:BD-EuGRF5+AD/BD+AD-EuGIF1
Fig. 7 Yeast two-hybrid assay for protein-protein interaction between EuGIF1 and EuGRF5SD/-LT: Synthetic dropout medium deficient in leucine (-L) and tryptophan (-T). SD/-LTAH/X-α-Gal: Stringent selection medium with quadruple dropout (-L/-T/-A/-H) supplemented with 5-bromo-4-chloro-3-indolyl-α-D-galactopyranoside (X-α-Gal). The indicated OD600 values (0.2, 0.02, 0.002, and 0.000 2) represent 10-fold serial dilutions of yeast cultures prior to spotting assay. Positive control: BD-P53+AD-T; negative control 1: BD-Lam+AD-T; test group: BD-EuGRF5+AD-EuGIF1; negative control 2: BD-EuGRF5+AD/BD+AD-EuGIF1

图8 EuGIF1对拟南芥gif1突变体的遗传互补A:遗传互补的T3代转基因植株的基因型鉴定结果;B:培养基上T3代转基因植株12 d的幼苗表型,箭头指示野生型、突变体及3株具有代表性的T3代纯合阳性转基因株系的幼叶,图中比例尺均为0.5 cm
Fig. 8 Genetic complementation of the A. thalianagif1 mutant by EuGIF1A: Genotyping results of T3 generation transgenic plants for the complementation test. B: Phenotypic characterization of 12 d T3 transgenic seedlings grown in medium, with arrows indicating the wild type, mutant, and three representative T3 homozygous positive transgenic lines for juvenile leaves. Scale bar: 0.5 cm
| [1] | Horiguchi G, Kim GT, Tsukaya H. The transcription factor AtGRF5 and the transcription coactivator AN3 regulate cell proliferation in leaf primordia of Arabidopsis thaliana [J]. Plant J, 2005, 43(1): 68-78. |
| [2] | Omidbakhshfard MA, Proost S, Fujikura U, et al. Growth-regulating factors (GRFs): a small transcription factor family with important functions in plant biology [J]. Mol Plant, 2015, 8(7): 998-1010. |
| [3] | Rodriguez RE, Ercoli MF, Debernardi JM, et al. Growth-regulating factors, a transcription factor family regulating more than just plant growth [M]// Plant Transcription Factors. Amsterdam: Elsevier, 2016: 269-280. |
| [4] | Debernardi JM, Tricoli DM, Ercoli MF, et al. A GRF-GIF chimeric protein improves the regeneration efficiency of transgenic plants [J]. Nat Biotechnol, 2020, 38(11): 1274-1279. |
| [5] | Feng Q, Xiao L, He YZ, et al. Highly efficient, genotype-independent transformation and gene editing in watermelon (Citrullus lanatus) using a chimeric ClGRF4-GIF1 gene [J]. J Integr Plant Biol, 2021, 63(12): 2038-2042. |
| [6] | Pan WB, Cheng ZT, Han ZG, et al. Efficient genetic transformation and CRISPR/Cas9-mediated genome editing of watermelon assisted by genes encoding developmental regulators [J]. J Zhejiang Univ Sci B, 2022, 23(4): 339-344. |
| [7] | 郭苏平, 田美萍, 丁静. GRF-GIF嵌合体在草莓遗传转化中的应用 [J/OL]. 分子植物育种, 2022. . |
| Guo SP, Tian MP, Ding J. Application of GRF-GIF Chimera in genetic transformation of strawberry [J/OL]. Mol Plant Breed, 2022. . | |
| [8] | Bull T, Debernardi J, Reeves M, et al. GRF-GIF chimeric proteins enhance in vitro regeneration and Agrobacterium-mediated transformation efficiencies of lettuce (Lactuca spp.) [J]. Plant Cell Rep, 2023, 42(3): 629-643. |
| [9] | Zhao Y, Cheng P, Liu Y, et al. A highly efficient soybean transformation system using GRF3-GIF1 chimeric protein [J]. J Integr Plant Biol, 2025, 67(1): 3-6. |
| [10] | Lee BH, Ko JH, Lee SM, et al. The Arabidopsis GRF-INTERACTING FACTOR gene family performs an overlapping function in determining organ size as well as multiple developmental properties [J]. Plant Physiol, 2009, 151(2): 655-668. |
| [11] | Kim JH, Kende H. A transcriptional coactivator, AtGIF1, is involved in regulating leaf growth and morphology in Arabidopsis [J]. Proc Natl Acad Sci USA, 2004, 101(36): 13374-13379. |
| [12] | Horiguchi G, Nakayama H, Ishikawa N, et al. ANGUSTIFOLIA3 plays roles in adaxial/abaxial patterning and growth in leaf morphogenesis [J]. Plant Cell Physiol, 2011, 52(1): 112-124. |
| [13] | Kanei MR, Horiguchi G, Tsukaya H. Stable establishment of Cotyledon identity during embryogenesis in Arabidopsis by ANGUSTIFOLIA3 and HANABA TARANU [J]. Development, 2012, 139(13): 2436-2446. |
| [14] | Lee BH, Wynn AN, Franks RG, et al. The Arabidopsis thaliana GRF-INTERACTING FACTOR gene family plays an essential role in control of male and female reproductive development [J]. Dev Biol, 2014, 386(1): 12-24. |
| [15] | Lee SJ, Lee BH, Jung JH, et al. GROWTH-REGULATINGFACTOR and GRF-INTERACTING FACTOR specify meristematic cells of gynoecia and anthers [J]. Plant Physiol, 2018, 176(1): 717-729. |
| [16] | Liu HH, Xiong F, Duan CY, et al. Importin β4 mediates nuclear import of GRF-interacting factors to control ovule development in Arabidopsis [J]. Plant Physiol, 2019, 179(3): 1080-1092. |
| [17] | Liu ZP, Li N, Zhang YY, et al. Transcriptional repression of GIF1 by the KIX-PPD-MYC repressor complex controls seed size in Arabidopsis [J]. Nat Commun, 2020, 11(1): 1846. |
| [18] | Li SC, Gao FY, Xie KL, et al. The OsmiR396c-OsGRF4-OsGIF1 regulatory module determines grain size and yield in rice [J]. Plant Biotechnol J, 2016, 14(11): 2134-2146. |
| [19] | He ZS, Zeng J, Ren Y, et al. OsGIF1 positively regulates the sizes of stems, leaves, and grains in rice [J]. Front Plant Sci, 2017, 8: 1730. |
| [20] | Shimano S, Hibara KI, Furuya T, et al. Conserved functional control, but distinct regulation, of cell proliferation in rice and Arabidopsis leaves revealed by comparative analysis of GRF-INTERACTING FACTOR 1 orthologs [J]. Development, 2018, 145(7): dev159624. |
| [21] | Zhang D, Sun W, Singh R, et al. GRF-interacting factor1 regulates shoot architecture and meristem determinacy in maize [J]. Plant Cell, 2018, 30(2): 360-374. |
| [22] | 崔迪. 玉米gif1突变体雄性不育的分子机理研究 [D]. 武汉: 华中农业大学, 2021. |
| Cui D. A study on molecular mechanism of male sterility in maize gif1 mutant [D]. Wuhan: Huazhong Agricultural University, 2021. | |
| [23] | 郑媛媛. 玉米GIF1基因调控雌花序形态建成和小花发育的分子机理研究 [D]. 武汉: 华中农业大学, 2019. |
| Zheng YY. A study on molecular mechanism of GIF1 in the regulation of female inflorescence architecture and floral development in maize [D]. Wuhan: Huazhong Agricultural University, 2019. | |
| [24] | Li MF, Zheng YY, Cui D, et al. GIF1 controls ear inflorescence architecture and floral development by regulating key genes in hormone biosynthesis and meristem determinacy in maize [J]. BMC Plant Biol, 2022, 22(1): 127. |
| [25] | 张立全, 张浩林, 李丛丛, 等. 谷子生长调节因子互作因子基因家族生物信息学分析 [J]. 福建农业学报, 2021, 36(8): 878-883. |
| Zhang LQ, Zhang HL, Li CC, et al. Bioinformatics of growth-interacting factor genes in foxtail millet [J]. Fujian J Agric Sci, 2021, 36(8): 878-883. | |
| [26] | 邱姗, 王文新, 江梅, 等. 杉木GRF和GIF基因家族鉴定、表达与互作分析 [J]. 核农学报, 2024, 38(7): 1224-1233. |
| Qiu S, Wang WX, Jiang M, et al. Identification, expression and interaction analysis of GRF and GIF gene families in Cunninghamia lanceolata [J]. J Nucl Agric Sci, 2024, 38(7): 1224-1233. | |
| [27] | 吴洁, 淮东欣, 薛晓梦, 等. 花生GRF和GIF基因家族的鉴定与表达分析 [J/OL]. 分子植物育种, 2023. . |
| Wu J, Huai DX, Xue XM, et al. Genome-wide identification and expression analysis of GRF and GIF gene families in peanut [J/OL]. Mol Plant Breed, 2023. . | |
| [28] | 杨宇琦. 胡杨GIF基因家族鉴定及PeGIF3对叶形调控的研究 [D]. 阿拉尔: 塔里木大学, 2024. |
| Yang YQ. Identification of GIF gene family and regulation of leaf shape by PeGIF3 in Populus euphratica [D]. Ala'er: Tarim University, 2024. | |
| [29] | 杜仲产业研究课题组. 杜仲生物产业发展现状与前景 [J]. 中国林业产业, 2022(11): 18-47. |
| Research Group of Eucommia ulmoides Industry. Present situation and prospect of Eucommia ulmoides biological industry development [J]. China For Ind, 2022(11): 18-47. | |
| [30] | Wuyun TN, Wang L, Liu HM, et al. The hardy rubber tree genome provides insights into the evolution of polyisoprene biosynthesis [J]. Mol Plant, 2018, 11(3): 429-442. |
| [31] | Li Y, Wei HR, Yang J, et al. High-quality de novo assembly of the Eucommia ulmoides haploid genome provides new insights into evolution and rubber biosynthesis [J]. Hortic Res, 2020, 7(1): 183. |
| [32] | Du QX, Wu ZX, Liu PF, et al. The chromosome-level genome of Eucommia ulmoides provides insights into sex differentiation and α-linolenic acid biosynthesis [J]. Front Plant Sci, 2023, 14: 1118363. |
| [33] | 王珞, 朱英, 赵德刚. 杜仲CRISPR/Cas9基因编辑系统的建立 [J]. 植物生理学报, 2023, 59(8): 1566-1574. |
| Wang L, Zhu Y, Zhao DG. An efficient CRISPR/Cas9 mutagenesis system for Eucommia ulmoides [J]. Plant Physiol J, 2023, 59(8): 1566-1574. | |
| [34] | Jumper J, Evans R, Pritzel A, et al. Highly accurate protein structure prediction with AlphaFold [J]. Nature, 2021, 596(7873): 583-589. |
| [35] | Evans R, O'Neill M, Pritzel A, et al. Protein complex prediction with AlphaFold-Multimer [J]. BioRxiv, 2022. DOI: https://doi.org/10.1101/2021.10.04.463034 . |
| [36] | Yan YM, Tao HY, He JH, et al. The HDOCK server for integrated protein-protein docking [J]. Nat Protoc, 2020, 15(5): 1829-1852. |
| [37] | Chen CJ, Chen H, Zhang Y, et al. TBtools: an integrative toolkit developed for interactive analyses of big biological data [J]. Mol Plant, 2020, 13(8): 1194-1202. |
| [38] | Wang RR, Lu N, Liu CG, et al. MtGSTF7, a TT19-like GST gene, is essential for accumulation of anthocyanins, but not proanthocyanins in Medicago truncatula [J]. J Exp Bot, 2022, 73(12): 4129-4146. |
| [39] | Zhou SL, Yang TQ, Mao YW, et al. The F-box protein MIO1/SLB1 regulates organ size and leaf movement in Medicago truncatula [J]. J Exp Bot, 2021, 72(8): 2995-3011. |
| [40] | Qin L, Chen HF, Wu QF, et al. Identification and exploration of the GRF and GIF families in maize and foxtail millet [J]. Physiol Mol Biol Plants, 2022, 28(9): 1717-1735. |
| [41] | Wu WQ, Li J, Wang Q, et al. Growth-regulating factor 5 (GRF5)-mediated gene regulatory network promotes leaf growth and expansion in poplar [J]. New Phytol, 2021, 230(2): 612-628. |
| [42] | Wang RR, Zhu Y, Zhao DG. Genome-wide identification and expression analysis of growth-regulating factors in Eucommia ulmoides oliver (du-Zhong) [J]. Plants, 2024, 13(9): 1185. |
| [43] | 何文广, 苏印泉, 徐咏梅, 等. 外源激素影响杜仲叶中次生代谢物含量的研究 [J]. 西北林学院学报, 2009, 24(6): 121-123. |
| He WG, Su YQ, Xu YM, et al. Effects of external hormones on secondary metabolites in the leaf of Eucommia ulmoides [J]. J Northwest For Univ, 2009, 24(6): 121-123. | |
| [44] | 徐咏梅. 外源激素对杜仲次生代谢物含量的影响 [D]. 杨凌: 西北农林科技大学, 2007. |
| Xu YM. The effect of external hormones on the content of secondary metabolites in Eucommia ulmoides Oliv [D]. Yangling: Northwest A & F University, 2007. | |
| [45] | 张强, 苏印泉, 徐咏梅. 采样时间对赤霉素处理杜仲叶次生代谢物含量的影响 [J]. 西北林学院学报, 2010, 25(6): 130-133. |
| Zhang Q, Su YQ, Xu YM. Effect of harvesting time on contents of secondary metabolites in the leaf of Eucommia ulmoides treated by gibberellin acid [J]. J Northwest For Univ, 2010, 25(6): 130-133. | |
| [46] | 魏艳秀, 刘慧东, 杜红岩, 等. 外源激素提高杜仲叶中有效成分含量的效果 [J]. 中南林业科技大学学报, 2017, 37(5): 42-49. |
| Wei YX, Liu HD, Du HY, et al. Efficacy of exogenous hormones enhancing active ingredients in Eucommia ulmoides leaves [J]. J Cent South Univ For Technol, 2017, 37(5): 42-49. |
| [1] | 程婷婷, 刘俊, 王利丽, 练从龙, 魏文君, 郭辉, 吴尧琳, 杨晶凡, 兰金旭, 陈随清. 杜仲查尔酮异构酶基因家族全基因组鉴定及其表达模式分析[J]. 生物技术通报, 2025, 41(9): 242-255. |
| [2] | 覃悦, 杨妍, 张磊, 卢丽丽, 李先平, 蒋伟. 二倍体和四倍体马铃薯StGAox基因鉴定与比较分析[J]. 生物技术通报, 2025, 41(3): 146-160. |
| [3] | 段若昕, 陈盈盈, 林金星, 李瑞丽. 种子休眠及其调控机制研究进展[J]. 生物技术通报, 2025, 41(12): 16-26. |
| [4] | 吴丁洁, 陈盈盈, 徐静, 刘源, 张航, 李瑞丽. 植物赤霉素氧化酶及其功能研究进展[J]. 生物技术通报, 2024, 40(7): 43-54. |
| [5] | 金云倩, 王彬, 郭书磊, 赵霖熙, 韩赞平. 赤霉素调控玉米种子活力的研究进展[J]. 生物技术通报, 2023, 39(1): 84-94. |
| [6] | 李毅丹, 单晓辉. 赤霉素代谢调控与绿色革命[J]. 生物技术通报, 2022, 38(2): 195-204. |
| [7] | 黎猛, 陈跃, 胡凤荣. miR159-GAMYB途径调控植物生长发育的研究进展[J]. 生物技术通报, 2021, 37(9): 234-247. |
| [8] | 郑伟, 周涛, 江维克, 李军, 肖承鸿, 杨昌贵, 张晨, 龚安慧, 韦德群, 毕艳. 外源PBZ和GA3对太子参发育过程内源IAA积累及其相关基因表达的影响[J]. 生物技术通报, 2019, 35(2): 46-52. |
| [9] | 高秀华, 傅向东. 赤霉素信号转导及其调控植物生长发育的研究进展[J]. 生物技术通报, 2018, 34(7): 1-13. |
| [10] | 何依雪, 刘文, 沈祥陵. GA与B9对马铃薯种薯生长发育的影响[J]. 生物技术通报, 2018, 34(7): 66-73. |
| [11] | 何依雪, 刘文, 沈祥陵. 蔗糖,GA与液体培养基对马铃薯块茎形成的影响[J]. 生物技术通报, 2018, 34(7): 74-80. |
| [12] | 凌婷 ,杨树萍 ,魏煜凡, 张琳. 2,4-表油菜素内酯和赤霉素对微拟球藻产油率及脂肪酸组成的影响[J]. 生物技术通报, 2018, 34(6): 178-182. |
| [13] | 杨意宏, 徐浩, 陈段芬, 高志民. 高等植物赤霉素3-β-双氧化酶基因研究进展[J]. 生物技术通报, 2018, 34(3): 18-22. |
| [14] | 罗岸, 陈克强. 离体培养条件下GA对烟草胚柄PCD的诱导研究[J]. 生物技术通报, 2017, 33(3): 71-77. |
| [15] | 王文然, 樊秀彩, 张文颖, 刘崇怀, 房经贵, 王晨. 果树赤霉素代谢与信号途径研究进展[J]. 生物技术通报, 2017, 33(11): 1-7. |
| 阅读次数 | ||||||
|
全文 |
|
|||||
|
摘要 |
|
|||||